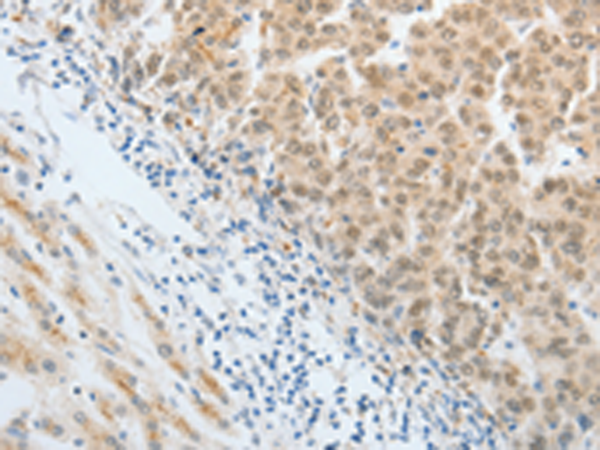

-
分类: 科研抗体货号: P11064别名: FOX3; NEUN; FOX-3; HRNBP3应用: WB,IHC反应种属: Human, Mouse
-
分类: 科研抗体货号: P11065别名: CSPG3应用: WB,IHC反应种属: Human, Mouse, Rat
-
分类: 科研抗体货号: P11085别名: FSGS7; PAPRS应用: WB反应种属: Human, Mouse
-
分类: 科研抗体货号: P11063别名: HA95, HAP95, NAKAP, NAKAP95应用: WB,IHC反应种属: Human, Mouse
-
分类: 科研抗体货号: P11083别名: PAR6; PAR6C; TAX40; PAR-6A; TIP-40; PAR6alpha应用: WB反应种属: Human
-
分类: 科研抗体货号: P11062别名: AKAP-8, AKAP95, AKAP 95, AKAP-95应用: WB,IHC反应种属: Human
-
分类: 科研抗体货号: P11080别名: LPP1; PAP2; LLP1a; PAP-2a; PPAP2A应用: WB,IHC反应种属: Human, Mouse, Rat
-
分类: 科研抗体货号: P11059别名: GRB4; NCKbeta应用: WB,IHC反应种属: Human, Mouse
-
分类: 科研抗体货号: P11079别名: LPA4, P2Y9, GPR23, P2RY9, P2Y5-LIKE应用: WB,IHC反应种属: Human, Mouse, Rat
-
分类: 科研抗体货号: P11057别名: CDHN; NCAD; CD325; CDw325应用: IHC反应种属: Human, Mouse, Rat

鄂公网安备42018502007531号
鄂公网安备42018502007531号

